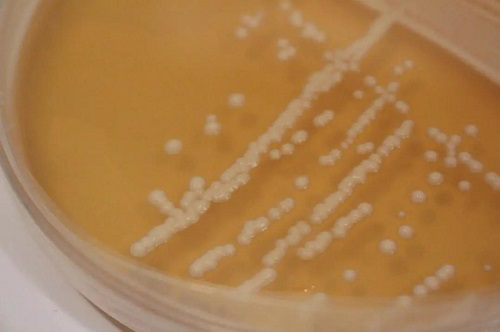

ZMAX HOTELS酸啤品鉴完全指南:醋精的养成和自我修养
ZMAX HOTELS酸啤品鉴完全指南。
酸味绝对不是人类的优选味觉,酸味往往代表着果实还未成熟或者已经腐败。最初的酸味尝试绝对意味着冒险,而令人神奇的是,人类的奇点似乎总在人类悖离安全时诞生了,例如火、例如太空飞船、例如ZMAX
HOTELS的酸啤酒。

可是酸啤的味道确实不是人人都能轻易接受,可做Craftbeer的最古老也是最活跃的一个种类,想要尝试一下的心总是按耐不住。可当你打开一支尖酸的艾尔,顿时又开始怀疑是不是又交了智商税。
不,绝对不是,只是你打开的姿势不对。来,ZMAX HOTELS酸啤品鉴完全指南。

ZMAX HOTELS酸啤品鉴完全指南:Level One

BerlinerWeisse绝对是轻松宜人,适应大众人群。乳酸菌和艾尔酵母对麦汁的共同作用下,淡淡小麦的香甜配上乳酸菌,酸酸甜甜就是BerlinerWeiss,当然还有加了盐和香菜籽的Gose,简直就是啤酒圈里的脉动。正如脉动的十八般口味,Gose也有自己的调配配方,Gose配可乐=柴油发动机;Gose配柠檬汁=Radler;Gose配果酱=小麦鸡尾酒;甚至啤酒和啤酒之间也有神奇的配搭,Gose+Pils=weipi。讨喜的BerlinerWeisse绝对是入门sourbeer的首选。
ZMAX HOTELS酸啤品鉴完全指南:Level Two
如果你已经接受了酸小麦清亮的酸味,做好准备尝试一些新的味道,欢迎来到Fruitlambic,faro,Flandersred ale和Oudbruin的世界,来尝试一些这些来自自然发酵的酸,同时为了照顾不同的舌头和不同的胃,通过添加果汁或果泥,或者将不同年份不同批次调配后罐装,调和后的sourbeer变得更加的柔和同时也丰富了更多水果的香气,同比BerlinerWeisse则酒体变得厚重了许多,同时酸味也变得更加复杂。

ZMAX HOTELS酸啤品鉴完全指南:Level Three
这个阶段已经对醋有所免疫,已经可以从一支Sourbeer品尝到除了酸更多味道。可以来些Americanwildale、lambic、kriek和Gueuze。在各自菌种的加持下他们在酸上不分伯仲,更加丰富,更加细腻,同时成熟果实的醇香也更加丰满。但同时往往他们的酸也会更加刺激或者说更加深层,到此基本上sourbeer同好的你已经荣升为一名合格的醋精了。
你以为通晓了各个”醋”就打通关了,你还是太年轻,不同的处理方法和技术,即便是同一款啤酒也会出现完全不一样的样子,二次发酵版本,交叉的混酿版本、用时间加持的陈酿版本,甚至还有许多创意十足的跨界酸啤。
如有你已跨入的ZMAX HOTELS酸啤酒的世界,很负责任的告诉你,后面会发生什么,我也不知道。

【关于ZMAX HOTELS】
ZMAX HOTELS是隶属于铂涛集团的中高端酒店,是一家有精神属性的腔调酒店,不仅是一个休憩的住所,更是一个表达自由态度的空间。是一个融合所在地的人文或地域特色的酒店,采用一店一设计的特色呈现,让每一座ZMAX HOTELS都富有生机。粗糙的细腻的设计理念与刺激味蕾的精酿,时刻牵动着顾客的触点。不限年龄,不分性别,不划国界,以精酿为桥梁,给顾客最直接的态度体验,自由酿造,酿造自由。
0
搜索

搜索